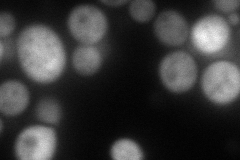
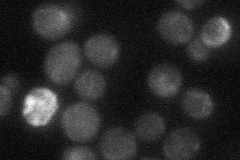
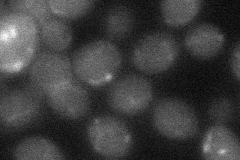

View description
Putative protein of unknown function; GST fusion protein is a Dbf2-Mob1 phosphoylation target in a proteome chip analysis; synthetic lethal with PH085 deletion; plays a role in restricting Ty1 transposition
Localization:
Intensity:
Fold change:
Significance:
-
C’ GFP library in SD

below threshold17.12 -
N' NOP1pr-GFP in SD

cytosol,punctate110.962 -
N' TEF2pr-mCherry in SD
cytosol126.325 -
N' NATIVEpr-GFP in SD
cytosol24.6333 -
N' TEF2pr-VC and Cyto-VN in SD
cytosol31.1043 -
C’ GFP library in SD+DTT

cytosol17.181No -
C’ GFP library in SD+H2O2

cytosol18.351.07No -
C’ GFP library in Starvation Media

cytosol19.191.12No -
C’ GFP library on the background of Pup2-DaMP

below threshold -
C’ GFP library on the background of CCT mutant

below threshold16.76610.978692No
